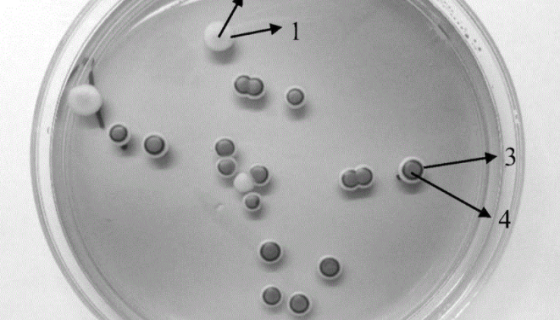
马克斯克鲁维酵母的优势与培养及注意事项有哪些？

人肺微血管内皮细胞接收后的操作流程与注意事项!
人肺微血管内皮细胞分离自肺组织;肺是机体的呼吸器官,位于胸腔...

CMCC(B)45108 产气肠杆菌的保藏与注意事项!
产气肠杆菌(Enterobacter aerogenes)系...

小鼠胰岛素瘤胰岛Β细胞的处理方法与培养步骤!
小鼠胰岛素瘤胰岛Β细胞来源于转基因小鼠中生长的一个胰肿瘤(胰...

酿酒酵母的菌株分类与功能物质及筛选鉴定!
酿酒酵母是与人类关系最广泛的一种酵母,用于制作面包和馒头等食...

小鼠T淋巴细胞HT-2的复苏与传代及冻存操作说明!
小鼠T淋巴细胞HT-2取自BALB/c小鼠,此为白介素2依赖...
马克斯克鲁维酵母的优势与培养及注意事项有哪些?
马克斯克鲁维酵母是Kluyveromyces属的微生物,原产...

HMC3 (人小胶质细胞)的处理方法与培养步骤!
人小胶质细胞的处理方法与培养步骤及注意事项有哪些?

纯黄丝衣霉的培养条件与注意事项及保藏方法!
纯黄丝衣霉是Byssochlamys属的微生物,原产地为英国...

LOVO/5FU 人结直肠癌细胞氟尿嘧啶耐药株
人结直肠癌细胞氟尿嘧啶耐药株的运输与保存及培养步骤。